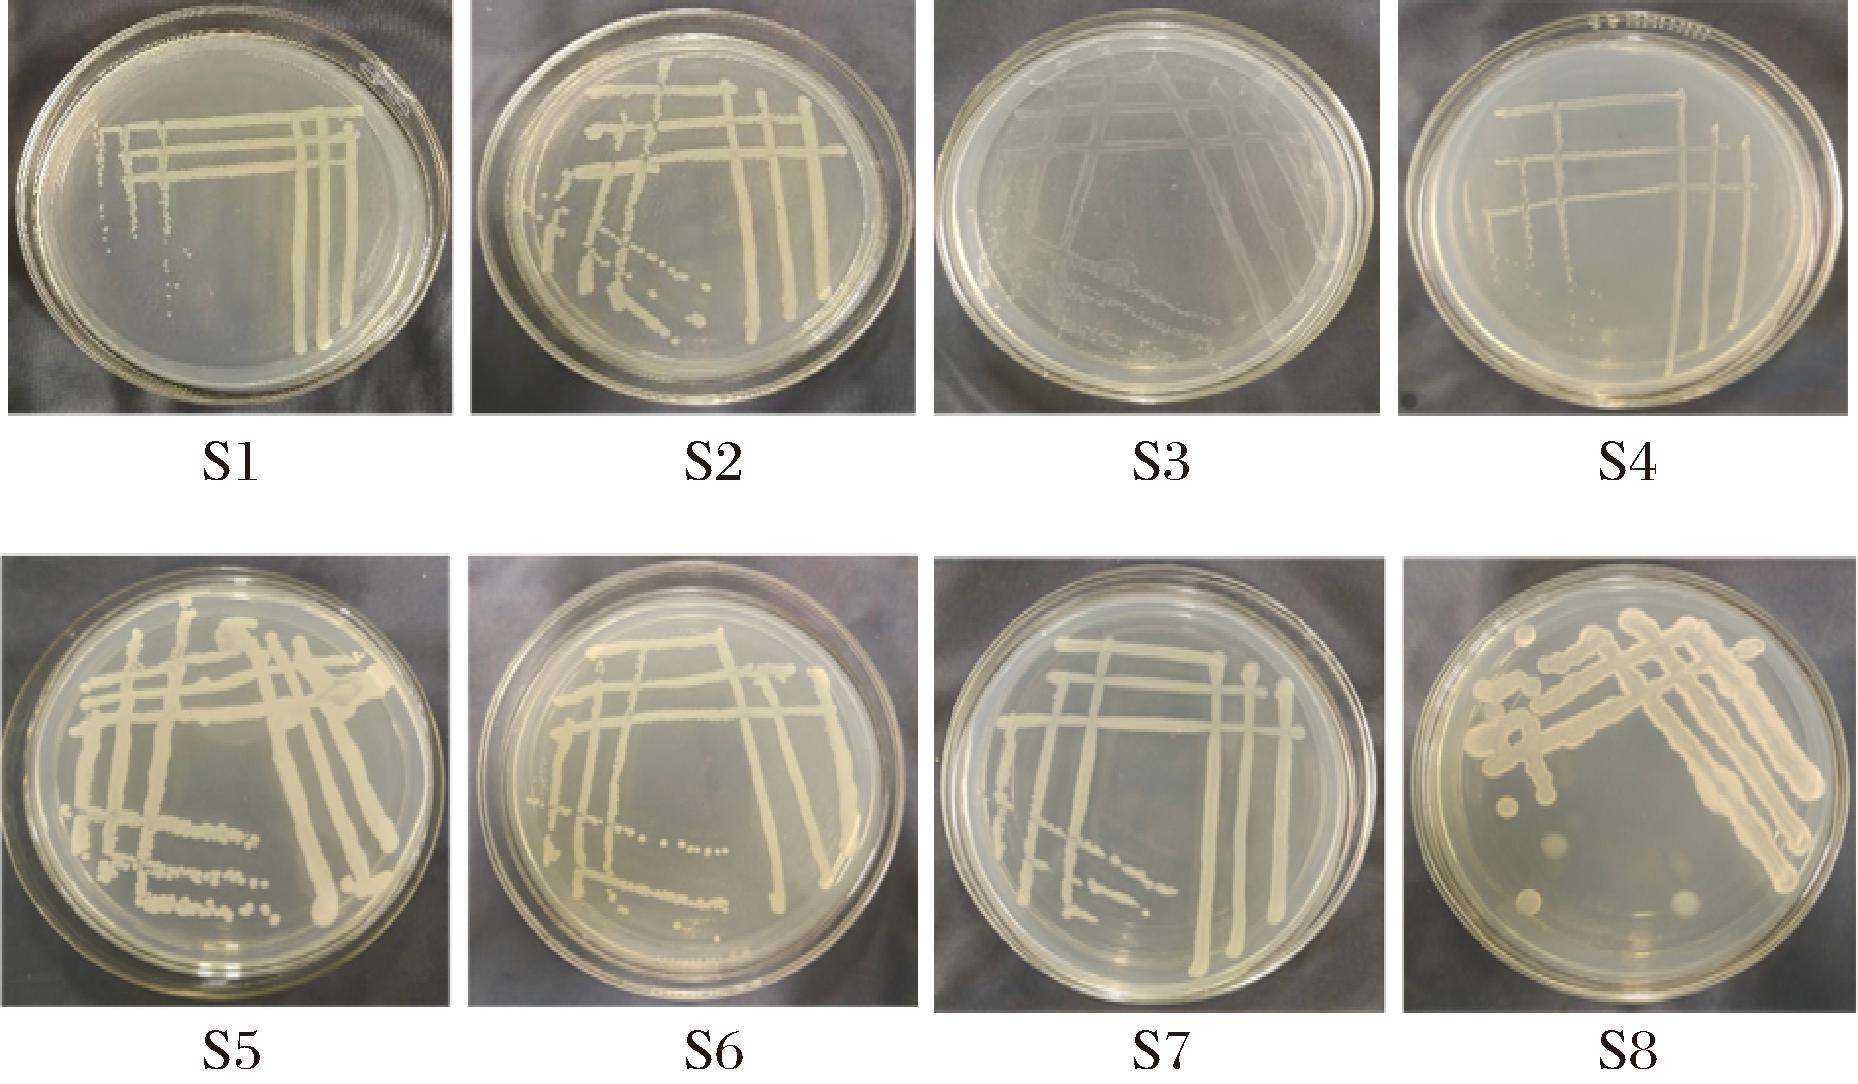

包浆豆腐是一道源自云南的特色小吃,以其独特的口感而闻名。所谓包浆,就是豆腐的外层烤熟之后,内层依旧是浆液。包浆豆腐可油炸可烧烤,口感咸香,入口汁水滑嫩,吃起来汁液四溅,外酥里嫩,口感味道极佳[1]。目前,包浆豆腐主要以冷链且散装方式下销售,保鲜方式单一,货架期很短,严重影响包浆豆腐产业的发展。包浆豆腐的生产,很多地方以原始的手工作坊模式进行初级生产,大豆原料清洗不净、制作豆腐的水源质量及相关工艺参数不稳定等问题导致包浆豆腐容易滋生腐败菌,影响包浆豆腐的保质期,该问题已经成为制约包浆豆腐产业发展的瓶颈问题,然而与其相关的腐败微生物研究较少,因而亟需了解包浆豆腐生产和贮藏过程中的腐败菌及其腐败机理。
目前,国内外已有关于大豆与豆制品腐败菌及其腐败机理的研究[2]。韩翠萍等[3]从东北盒装豆腐中分离出的主要微生物为溶血性葡萄球菌(Staphylococcus haemolyticus)、克假丝酵母(Candida krusei)、短芽孢杆菌(Brevisbacillus choshinensis)、托尔豪特链球菌(Streptococcus thoraltensis),并发现溶血性葡萄球菌(Staphylococcus haemolyticus)、克假丝酵母(Candida krusei)、托尔豪特链球菌(Streptococcus thoraltensis)是导致豆腐发黏、胀袋以及变软的主要微生物,但是短芽孢杆菌(Brevisbacillus choshinensis)并未对豆腐的品质有明显影响。袁春红等[4]从变质的豆腐干中分离出一株优势腐败菌,该菌经鉴定为枯草芽孢杆菌(Bacillus subtilis),回接后发现其对豆腐干的质构,腐败相关化学成分均有显著影响。彭鑫等[5]在湘味卤豆干中分离出9种腐败菌,并通过回接的腐败现象确定其中的枯草芽孢杆菌(Bacillus subtilis),蜡样芽孢杆菌(Bacillus cereus)是引起湘味卤豆干腐败的主要优势菌。杨明等[6]通过对散装老豆腐以及盒装内酯豆腐中腐败微生物的分离和鉴定,发现发酵粘液乳杆菌(Limosilactobacillus fermentum)可以使老豆腐发黏,而梨形肠杆菌(Enterobacter pyrinus)对两类豆腐都具有产气的作用,产生胀袋现象。WANG等[7]从腐败的全脂豆腐中分离出2种主要腐败菌,鉴定为枯草芽孢杆菌(Bacillus subtilis)和蜡样芽孢杆菌(Bacillus cereus)。海丹等[8]以临期盒装豆腐为研究对象,分离出来了植生拉乌尔菌(Raoultella planticola)和沃纳利葡萄球菌(Staphylococcus warneri),发现这2种菌是导致临期豆腐出现腐败现象的优势腐败菌。
本研究以云南石屏生产的包浆豆腐为研究对象,对其腐败微生物进行分离纯化并通过形态学观察以及16S rDNA进行鉴定;将分离鉴定后的腐败菌进行回接实验,观察包浆豆腐腐败性状的变化,同时以总酸为测定指标,确定不同腐败菌对包浆豆腐的影响,以期为包浆豆腐质量的精准评价提供理论依据以及后续包浆豆腐保鲜技术的开发提供理论基础。
1 材料与方法
1.1 材料与试剂
云南石屏包浆豆腐,市售;革兰氏染色试剂盒,常德市比克曼生物公司;PCA培养基(平板计数琼脂培养基),北京奥博星生物科技有限责任公司;LB液体培养基,实验室自制;DNA提取试剂盒,上海派森诺生物科技股份有限公司;PCR扩增引物,上海派森诺生物科技股份有限公司。
1.2 仪器与设备
Gl5DS立式高温高压蒸汽灭菌锅,厦门致微有限公司;TXZ-100恒温培养箱,苏州捷美电子有限公司;SWCJ-2FD超净工作台,江苏通净净化设备有限公司;XP-213电子显微镜,南京宇凡仪器科技有限公司;Milli-ROPLUS30超纯水仪,Kertone科技有限公司;ABI-2720 PCR仪,美国Applied Biosystems 公司;Mini Pro 300V Power Supply电泳仪,major science.,USA。
1.3 实验方法
1.3.1 腐败菌的分离纯化
将市售包装好的云南石屏包浆豆腐放置在室温下,使其在自然室温中腐败变质;4 d后,包浆豆腐已经达到感官无法接受的程度,包装已经胀气,包装袋中的包浆豆腐已经腐败变质为豆腐渣状,并且发出浓烈的腐败臭味。
在无菌条件下,随机取25 g上述腐败豆腐制品于无菌均质袋中,放入225 mL的无菌生理盐水中,振荡摇匀后配制浓度梯度为10-1样液,吸取1 mL此样液加入到9 mL无菌生理盐水中,依次类推将样液进行10倍稀释。
将配制好的适宜浓度梯度的样液吸取0.1 mL加入已凝固的无菌PCA培养皿中,用涂布棒将样液均匀涂布在培养基上;每个样液梯度做3个平行,将涂布好的培养皿放入37 ℃的恒温培养箱中,培养24 h。
在已培养24 h的培养基中,用无菌接种环挑取其中典型的单个菌落,接种至无菌PCA培养基中继续培养,采用平板划线法将挑取的单个菌落纯化分离3~5代,将纯化后得到的纯种腐败菌保存到无菌甘油管中,-40 ℃冰箱冷冻保藏。并且对纯化后的腐败菌利用革兰氏染色法进行镜检,在显微镜下进一步观察菌体形态。
1.3.2 腐败菌的菌种鉴定
微生物基因组DNA的提取参照试剂提取盒说明书[9]。细菌16S rDNA基因的PCR扩增采用正向引物为27F(5-AGAGTTTGATCCTGGCTCAG-3),反向引物为1492R(5-GGTTACCTTGTTACGACTT-3),扩增体为50 μL,扩增片段为1 500 bp。
PCR反应程序:预变性95 ℃,5 min;变性95 ℃,30 s;退火58 ℃,30 s;延伸72 ℃,1 min 30 s;终延伸72 ℃,7 min;循环次数为35次。
扩增产物用1%琼脂糖凝胶电泳检测,将PCR产物送至南京派森诺基因科技有限公司进行测序。
将得到的序列结果在NCBI网站上进行Blast比对,并用MEGA6.0软件构建系统发育树。
1.3.3 腐败菌回接
原料预处理:将包浆豆腐热水浴加热15 min,减少起始带菌量。
腐败菌回接:用接种环挑取纯化后的腐败菌到LB液体培养基中,37 ℃恒温摇床培养12 h收集菌悬液,用离心机离心后加入无菌生理盐水洗涤,重复2~3次,得到的菌液用无菌生理盐水调节浓度至105 CFU/mL。
分别吸取1 mL含菌量为105 CFU/mL的不同腐败菌菌液,接种至装有30 g样品的无菌包装袋,真空包装。将接菌后的样品放入37 ℃的恒温培养箱中,连续观察样品的腐败现象并检测总酸度变化。
1.3.4 总酸测定
参照GB/T 12456—2021《食品安全国家标准 食品中总酸的测定》方法测定。
1.3.5 包浆豆腐胀袋、变软及发臭指标的判定
包浆豆腐腐败程度的判定标准如表1所示。
表1 包浆豆腐胀袋、变软及发臭指标的判定
Table 1 Determination of swelling, softening, and odor indicators for tofu wrapped in slurry

评定指标评定标准程度0<膨胀系数<0.5+胀袋0.5≤膨胀系数<1.0++膨胀系数≥1.0+++豆腐质地欠细腻、偏软#变软豆腐质地差、弹性差##豆腐质地松散,无弹性###豆腐无豆香味、有少量臭味△发臭豆腐有大量的臭味△△豆腐臭味非常浓烈△△△
注:-:无明显变变化;+:产气胀袋;#:变软;△:发臭;符号数量代表变化程度;膨胀系数=(包装袋膨胀后体积-包装袋膨胀前体积)/包装袋膨胀前体积。
1.4 数据处理与分析
每个实验重复3次,结果以“平均值±标准差”表示。使用SPSS 23.0软件进行数据分析,Origin 2021软件进行绘图,通过Duncan’s进行显著性分析,P<0.05表示数据间有显著性差异。
2 结果与分析
2.1 腐败菌分离及形态特征
采用平板划线法对腐败的包浆豆腐产生的腐败菌进行分离纯化,挑取单个菌落进行革兰氏染色并镜检。根据菌落颜色、形态以及镜检的微观结构共筛选出8株菌种,命名为S1、S2、S3、S4、S5、S6、S7、S8。
如图1和图2所示,S1菌落呈圆形,边缘整齐,有光泽,呈淡黄色,镜检为短杆状,杆体边缘有些透明,呈米粒状,革兰氏染色为阴性;S2菌落呈圆形,边缘比较整齐,颜色为乳白色,表面有光泽,呈半透明状,菌体呈短杆状,革兰氏染色为阴性;S3菌落呈圆形、边缘整齐、表面湿润光滑,呈透明状,菌体呈长杆状,革兰氏染色为阴性;S4菌落呈圆形,边缘整齐,表面光滑,凸起,颜色为乳白色,菌体呈球状,革兰氏染色为阳性;S5菌落呈圆形,边缘整齐,有光泽,颜色为乳白色,菌体呈短杆状,革兰氏染色为阴性;S6菌落呈圆形,边缘整齐,有凸起,表面光滑且明亮,菌落湿润,颜色为乳白色,革兰氏染色为阴性;S7菌落呈圆形,边缘整齐,表面形成不规则扁平花纹,呈半透明状,革兰氏染色为阴性,菌体呈两端钝圆的短杆状,用接种环挑取时有拉丝现象;S8菌落呈圆形,边缘呈规则凸起,表面光滑,呈白色半透明状,菌体呈长杆状革兰氏染色为阳性。
图1 8株菌在PCA培养基上的菌落形态图
Fig.1 Colony morphology of eight strains of bacteria on PCA medium

图2 8种腐败菌细胞形态图(目镜10×物镜100×)
Fig.2 Morphology of eight spoilage bacteria
2.2 分子生物学鉴定
经过基因组DNA的提取,以总DNA为模版,通过27F/1492R引物,PCR扩增,琼脂糖凝胶电泳操作后,得到的8株菌在1500 bp出现特异条带(图3)。将8株腐败菌的测序结果上传至NCBI网站进行Blast比对,发现S1与变形杆菌处于一支,鉴定为变形杆菌(Proteus terra);S2经鉴定为嗜水气单胞菌(Aeromonas hydrophila);S3经鉴定为异常嗜糖气单胞菌(Aeromonas allosaccharophila),S2与S3聚于一枝,亲缘关系较近;S4与屎肠球菌聚与一枝,亲缘关系最近,鉴定为屎肠球菌(Enterococcus faecium);S5经鉴定为产酸克雷伯氏菌(Klebsiella oxytoca);S6鉴定为罗根肠杆菌(Enterobacter quasiroggenkampii);S7经鉴定为弗格森埃希菌(Escherichia bacterium);S8与芽孢杆菌所属一支,经鉴定为中村芽孢杆菌(Bacillus nakamurai)。

图3 PCR扩增凝胶电泳图
Fig.3 PCR amplification gel electrophoresis
将8株腐败菌的测序结果上传至NCBI网站进行Blast比对,并将其与8株菌的模式菌采用MEGA6.0的NJ法构建系统发育树[5](图4)。发现S1与Proteus mirabilis strain ATCC 29906(NR 114419.1)处于同一分枝,同源性为100%;S2与Aeromonas hydrophila strain ATCC(NR 118944.1)处于同一分枝,同源性达100%;S3与Aeromonas veronii bv.veronii strain ATCC 35624(NR 118947.1)处于同一分枝,同源性达100%;S4与Enterococcus mundtii strain ATCC 43186(NR 024906.1)处于同一分枝,同源性为100%;S5与Klebsiella oxytoca strain ATCC 13182(NR 041749.1)同处一分支,同源性为100%;S6与Enterobacter cloacae strain ATCC 13047(NR 102794.2)处同一分支,同源性为98%;S7与Escherichia fergusonii ATCC 35469 (NR 027549.1)处同一分枝,同源性为100%;S8与Bacillus licheniformis strain ATCC 14580(NR 074923.1)处于同一分支,同源性为100%。

图4 8株菌的系统发育树
Fig.4 Phylogenetic trees of eight pathogenic strains
在分离鉴定出的以上细菌中,变形杆菌是自然界广泛分布的一种致病菌,从土壤、水,食物中都可以分离出来,也可以从一些哺乳动物、鸟类以及爬行动物的肠道中分离得到,在一些被污染的医疗器械中也可分离得到[10];变形杆菌也广泛分布在人体的肠道中以及腐败有机物中[11],是一种人畜共患的条件致病菌[12]。推测该菌可能来自于原料大豆以及包浆豆腐在生产过程中使用的水,也可能是在生产过程中被工人污染。嗜水气单胞菌是一种可导致人畜共患传染病的细菌,多存在于自然界的多种水体中,湖泊、河流、温泉以及未经处理的市供水中都有它的身影[13],是一种主要的淡水鱼类病原菌[14]。罗会平等[15]发现一起疑似嗜水气单胞菌引起的食物中毒事件,经化验发现,在涉事学校食堂的食材、餐具和自来水末梢中均检测出大量的嗜水气单胞菌;由此,推测本次在包浆豆腐中分离出的该菌可能来源于包浆豆腐的生产环境以及生产时使用的水,也可能是在生产时被生产工人污染。异常嗜糖气单胞菌是一种广泛存在于自然界土壤、水体、蔬菜、水生生物体中的细菌,可导致鱼儿染病,造成养殖损失[16];该菌极有可能来自于原料大豆,包浆豆腐生产环境以及生产时使用的当地的水。屎肠球菌是动物肠道中常见的一种菌,对环境适应力和抵抗力强[17]。李博[18]发现屎肠球菌是GDL豆腐腐败变质的主要微生物;彭鑫等[5]也在湘味卤豆干中分离出屎肠球菌,与本实验的结果一致。屎肠球菌主要来源于原料大豆的外表面和表皮[2],也可能是包浆豆腐生产环境卫生不合格,在加工时被污染。产酸克雷伯菌是一种致病菌,在人和动物肠道比较常见,曾在经巴氏灭菌的牛奶中被分离出来过[19],推测可能来源于包浆豆腐的生产环境,或者被生产工人污染。CHEN等[20]发现罗根肠杆菌是水稻根系中的内生菌之一,可能来源于包浆豆腐的原材料大豆。弗格森埃希菌多存在于环境以及人和动物的肠道中,是人和动物少见的条件致病菌[21]。MEI等[22]曾在鸡肉中检测出,推测该菌可能来源于包浆豆腐的生产环境、车间的员工。中村芽孢杆菌被SHAIKH等[23]在土壤中分离出。康雪梅等[24]在固态食醋也曾分离出,并发现它可以提高出醋率,结合可推测该菌可能来源于原料大豆或包浆豆腐生产时使用的水。综上所述,原料大豆、包浆豆腐生产过程中所用的水源、生产环境和车间的员工可能是导致包浆豆腐被污染的重要因素。目前包浆豆腐的生产没有出台统一执行的卫生标准。在包浆豆腐的生产中, 可以运用食品中的各种质量管理体系, 严格把关人员与环境的卫生安全, 防止腐败微生物对包浆豆腐的污染。
2.3 腐败菌回接现象及腐败现象分析
2.3.1 腐败菌回接现象
如表2所示,将上述分离纯化出的8种腐败菌回接到包浆豆腐中,观察腐败现象,根据表中的实验结果表明随着贮藏时间的延长,包浆豆腐出现胀袋,发软,发臭等腐败现象。接种变形杆菌S1,屎肠球菌S4与罗根肠杆菌S6的豆腐出现明显的发臭腐败性状,接种后的豆腐失去原有的豆香味,产生少量的豆腐腐败臭味;接种产酸克雷伯菌S5与中村芽孢杆菌S8的豆腐产生了严重的豆腐腐败臭味;变形杆菌S1与屎肠球菌S4,产酸克雷伯菌S5,罗根肠杆菌S6,中村芽孢杆菌S8是包浆豆腐发臭的相关微生物。彭鑫等[5]在湘味卤豆干中发现枯草芽孢杆菌(Bacillus subtilis)、解淀粉芽孢杆菌菌(Bacillus amyloliquefaciens)、屎肠球菌(Enterococcus faecium)导致豆干产生臭味,本研究也发现屎肠球菌导致包浆豆腐发臭。关统伟等[25]发现导致豆干发臭的腐败菌为恶臭假单胞菌(Pseudomonas putida)。此外,也有研究者发现短小芽孢杆菌(Bacillus pumilus)[26]、短芽孢杆菌(Bacillus brevis)[27]、短稳杆菌(Brevibacterium brevis)[28]也是导致豆制品发臭的腐败微生物。
表2 腐败微生物回接腐败现象(37 ℃)
Table 2 The phenomenon of spoilage in microbial backtesting

保存时间/dS1S2S3S4S5S6S7S81------#2+△+-++△#++#3+△#+#+#+++△+△#++#++△#4+△#++#++##+++△++△△#++△#++#++△△##
注:-:无明显变化;+:产气胀袋;#:变软;△:发臭;符号数量代表变化程度。
接种嗜水气单胞菌S2与弗格森埃希菌S7的豆腐失去细腻,有弹性的原貌,豆腐组织变得掉渣、绵软;接种异常嗜糖气单胞菌S3和中村芽孢杆菌S8的豆腐出现较严重的腐败性状,其豆腐质地变得较松散,弹性差,掉渣及粘连情况较严重。嗜水气单胞菌S2与异常嗜糖气单胞菌S3,弗格森埃希菌S7,中村芽孢杆菌S8是包浆豆腐发软的相关微生物(表2)。彭鑫等[5]在湘味卤豆干中发现肺炎克雷伯氏菌(Klebsiella pneumoniae)、鲍氏不动杆菌(Acinetobacter baui)导致了湘味卤豆干发黏、质构变软。吴丽樱等[29]发现豆腐中肠膜明串珠菌(Leuconostoc mesenteroides)导致豆腐质构变软。有研究者发现解淀粉芽孢杆菌(Bacillus amyloliquefaciens)[29]、库特氏菌(Kurthia)[30]是导致内酯豆腐变软的主要菌种。
如表2所示,所有回接腐败菌的包浆豆腐均有胀袋现象,接种变形杆菌S1的豆腐包装的胀袋现象较轻;接种嗜水气单胞菌S2、异常嗜糖气单胞菌S3、产酸克雷伯菌S5、罗根肠杆菌S6、弗格森埃希菌S7、中村芽孢杆菌S8的豆腐包装胀袋情况较严重,包装袋出现明显较大的鼓包;接种屎肠球菌S4的胀袋情况最严重,包装袋已膨胀鼓起。彭鑫等[5]在湘味卤豆干中也发现屎肠球菌(Enterococcus faecium)引发了胀袋现象。LEE等[31]发现蜡样芽胞杆菌(Bacillus cereus)引发了豆腐的胀袋。研究显示,坚强芽孢杆菌(Bacillus firmus)[32]、产气肠杆菌(Enterobacter aerogenes)[28]也会引发豆腐胀袋的发生。
2.3.2 总酸度测定
回接腐败菌后,以未接种腐败菌的空白组为对照,在37 ℃贮藏条件下测定包浆豆腐总酸度的变化(图5)。结果表明,接种屎肠球菌S4与产酸克雷伯菌S5,弗格森埃希菌S7,中村芽孢杆菌S8的包浆豆腐的酸度显著高于接种变形杆菌S1与嗜水气单胞菌S2,异常嗜糖气单胞菌S3,罗根肠杆菌S6的包浆豆腐(P<0.05),所以屎肠球菌S4,产酸克雷伯菌S5,弗格森埃希菌S7,中村芽孢杆菌S8是包浆豆腐腐败变酸的主要微生物。韩翠萍等[3]发现托尔豪特链球菌(Streptococcus thoraltensis)是导致豆腐变酸的主要菌种。此外,短小芽孢杆菌( Bacillus pumilus)[26]、短芽孢杆菌(Bacillus brevis)[27]、产气肠杆菌(Enterobacter aerogenes)[28]和乳酸菌(Lactic acid bacteria)[33]也是导致豆制品变酸的菌种。

图5 腐败微生物回接实验的总酸度变化(37 ℃)
Fig.5 Changes of total acid of bacteria-inoculated Tofu(37 ℃)
注:柱状图上的不同字母表示腐败菌回接至豆腐后,总酸度在P<0.05 水平差异有统计学意义。
3 结论
通过对包浆豆腐中分离、纯化后的腐败菌株进行形态学观察、16S rDNA序列分析,最后得出分离菌株分别为变形杆菌(Proteus terrae)、嗜水气单胞菌(Aeromonas hydrophila)、异常嗜糖气单胞菌(Aeromonas allosaccharophila)、屎肠球菌(Enterococcus faecium)、产酸克雷伯菌(Klebsiella oxytoca)、罗根肠杆菌(Enterobacter quasiroggenkampii)、弗格森埃希菌(Escherichia fergusonii)、中村芽孢杆菌(Bacillus nakamurai),其中变形杆菌、屎肠球菌、产酸克雷伯菌、罗根肠杆菌和中村芽孢杆菌是包浆豆腐发臭的相关微生物;嗜水气单胞菌、异常嗜糖气单胞菌、弗格森埃希菌和中村芽孢杆菌是包浆豆腐发软的相关微生物,所有回接腐败菌的包浆豆腐均有胀袋现象。屎肠球菌、产酸克雷伯菌、弗格森埃希菌和中村芽孢杆菌是包浆豆腐腐败变酸的主要微生物。
[1] 杨玉美,汤鹏宇,黄道梅,等.生、熟浆工艺包浆豆腐挥发性风味物质差异分析[J].现代食品科技,2024,40(5):231-239.YANG Y M, TANG P Y, HUANG D M, et al.Analysis of differences in volatile flavor substances in soybean curd coated by raw and cooked pulping techniques [J].Modern Food Science and Technology,2024,40(5):231-239.
[2] 曲敏,陈红丽,王宇,等.传统豆制品腐败菌污染及抑制研究进展[J].食品科学技术学报,2022,40(3):167-178.QU M, CHEN H L, WANG Y, et al.Research progress of spoilage bacteria pollution and inhibition of traditional soy products[J].Journal of Food Science and Technology,2022,40(3):167-178.
[3] 韩翠萍,葛子榜,刘庆冠,等.豆腐中主要腐败菌的分离鉴定及与品质的相关性分析[J].中国食品学报,2019,19(7):283-291. HAN C P, GE Z B, LIU Q G, et al.Isolation and identification of main spoilage bacteria in tofu and its correlation with quality[J].Journal of Chinese Institute of Food Science and Technology, 2019, 19(7):283-291.
[4] 袁春红, 张庆, 向文良, 等.豆腐干优势腐败菌的分离鉴定及腐败特性分析[J].食品科技,2014,39(1):312-316.YUAN C H, ZHANG Q, XIANG W L, et al.Isolation, identification of dominant spoilage bacteria and measurement of spoilage characteristics in dried beancurd[J].Food Science and Technology, 2014,39(1):312-316.
[5] 彭鑫,李冰鑫,马芳,等.湘味卤豆干中腐败微生物的分离鉴定及控制[J].食品与机械,2024,40(4):172-178.PENG X, LI B X, MA F, et al.Isolation, identification and control of spoilage microorganisms in Xiangwei stewed bean[J].Food &Machinery,2024,40(4):172-178.
[6] 杨明, 陈信宇, 张辉,等.豆腐致腐细菌的分离鉴定及控制研究[J].食品工业科技,2014,35(12):218-221;225.YANG M, CHEN X Y, ZHANG H, et al.Separation, identification and control of spoilage bacteria in tofu[J].Science and Technology of Food Industry,2014,35(12):218-221;225.
[7] WANG C Z, DU Q L, YAO T W, et al.Spoilage bacteria identification and food safety risk assessment of whole soybean curd[J].Indian Journal of Microbiology, 2019, 59(2):250-253.
[8] 海丹,黄现青,乔明武,等.临期盒装豆腐腐败菌鉴定及抑菌效果评价[J].河南农业大学学报,2024,58(2):298-306.HAI D, HUANG X Q, QIAO M W, et al.Identification of spoilage bacteria in deadline boxed tofu and evaluation of their inhibitory effects [J].Journal of Henan Agricultural University,2024,58(2):298-306.
[9] 聂远洋,卢森,龚艺松,等.盒装豆腐的贮藏特性、腐败菌分离鉴定及腐败特性研究[J].食品工业科技,2023,44(21):137-145.NIE Y Y, LU S, GONG Y S,et al.Storage characteristics, isolation and identification of spoilage bacteria, and spoilage characters of boxed tofu[J].Science and Technology of Food Industry, 2023, 44(21):137-145.
[10] LUO R B, LIU B H, XIE Y L, et al.SOAPdenovo2:An empirically improved memory-efficient short-read de novo assembler [J].GigaScience, 2012, 1(1):2047-217X-1-18.
[11] 喻文俊.变形杆菌属食物中毒的特点与防控措施[J].中国医药指南,2017,15(9):291-292.YU W J.Characteristics and prevention measures of Proteus food poisoning[J].Guide of China Medicine,2017,15(9):291-292.
[12] 马亮,董靖,张国栋,等.克氏原螯虾源普通变形杆菌分离、鉴定及联合药敏试验[J].淡水渔业,2022,52(5):53-59.MA L, DONG J, ZHANG G D, et al.Identification and synergistic susceptibility of Proteus vulgaris isolated from Procambarus clarkii[J].Freshwater Fisheries,2022,52(5):53-59.
[13] KAUR S, KAUR H, KAUR B, et al.Isolating pathogenic multidrug-resistant Aeromonas hydrophila from diseased fish and assessing the effectiveness of a novel lytic Aeromonas veronii bacteriophage (AVP3) for biocontrol[J].Microbial Pathogenesis, 2024, 196:106914.
[14] 谢理, 高崧, 高清清,等.江苏人工养殖团头鲂嗜水气单胞菌感染的调查分析[J].动物医学进展,2021,42(11):125-128.XIE L, GAO S, GAO Q Q, et al.Investigation and analysis of Aeromonas hydrophila infection in Megalobrama amblycephala cultured in Jiangsu Province[J].Progress in Veterinary Medicine,2021,42(11):125-128.
[15] 罗会平,毛琦,依旺叫,等.一起嗜水气单胞菌引起的食源性疾病暴发事件调查[J].现代疾病预防控制,2023,34(11):880-884. LUO H P, MAO Q, YI W J, et al.Investigation on an outbreak of foodborne disease caused by Aeromonas hydrophila[J].Modern Disease Control and Prevention,2023,34(11):880-884.
[16] 张立强, 李媛, 魏朝辉, 等. 克氏原螯虾源异常嗜糖气单胞菌的分离鉴定[J]. 水产科技情报, 2018, 45(3):155-157; 161.ZHANG L Q, LI Y, WEI Z H, et al. The identificatication of Aeromonas allosaccharophila isolated from Procambarus clarkii[J]. Fisheries Science &Technology Information, 2018, 45(3):155-157; 161.
[17] GALUZA O A, EL’-REGISTAN G I, KANAPATSKIY T A, et al.Long-term survival of Enterococcus faecium under varied stabilization and cell immobilization conditions[J].Microbiology,2024,93(5):615-628.
[18] 李博. GDL豆腐中的主要腐败菌的研究及HACCP的建立[D].中国农业大学,2002.LI B.Study on the main spoilage bacterium and HACCP of GDL tofu[D].China Agricultural University,2002.
[19] 孟静,王锐.牛奶中一株产酸克雷伯菌的检出[J].食品工程,2010(3):53;56.MENG J,WANG R.The detection of Klebsiella oxytoca in the milk products[J].Food Engineering,2010(3):53;56.
[20] CHEN C, YANG B Y, GAO A X, et al.Transformation of arsenic species by diverse endophytic bacteria of rice roots[J].Environmental Pollution, 2022, 309:119825.
[21] TORKAN A, ASKARI BADOUEI M.Investigating the virulence-associated genes and antimicrobial resistance of Escherichia fergusonii Isolated from diseased ostrich chicks[J].Comparative Immunology, Microbiology and Infectious Diseases,2024,112,102226.
[22] MEI C Y, ZHANG X X, JIANG Y, et al.Characterisation of an IncX4 plasmid harbouring mcr-1 from Escherichia fergusonii from chicken meat in China[J].Journal of Global Antimicrobial Resistance, 2024, 37:8-10.
[23] SHAIKH I A, TURAKANI B, MALPANI J, et al.Extracellular protease production, optimization, and partial purification from Bacillus nakamurai PL4 and its applications[J].Journal of King Saud University-Science, 2023, 35(1):102429.
[24] 康雪梅,罗雯,郭建,等.固态食醋自然发酵醋醅中生淀粉酶产生菌的筛选及初步应用[J].中国调味品,2023,48(10):78-84.KANG X M, LUO W, GUO J, et al.Screening and preliminary application of raw amylase-producing bacteria in fermented grains by natural fermentation of solid-state vinegar[J].China Condiment,2023,48(10):78-84.
[25] 关统伟,赵辉平,张凤芳,等.传统豆腐干中主要腐败菌的分离及其系统发育[J].食品与发酵科技,2013,49(4):18-20;36.GUAN T W, ZHAO H P, ZHANG F F, et al.Isolation and phylogenetic diversity of spoilage microbe from dried bean curd[J].Food and Fermentation Technology,2013,49(4):18-20;36.
[26] 汪立平,张庆华,赵勇,等.变质豆浆中腐败微生物的分离与初步鉴定[J].微生物学通报,2007,34(4):621-624.WANG L P, ZHANG Q H, ZHAO Y, et al.Separation and preliminary identification of spoilage organisms in transmutative soy milk[J].Microbiology, 2007, 34(4):621-624.
[27] GANG S.Experimental study of microwave sterilizing pathogenic microbes in tofu[J].Advance Journal of Food Science and Technology, 2016, 11(7):534-536.
[28] 刘丽莎,彭义交,鲍鲁生,等.大豆浸泡过程中腐败微生物对豆浆品质的影响[J].食品科学,2015,36(14):161-164.LIU L S, PENG Y J, BAO L S, et al.Growth of spoilage microorganisms during soaking of soybean and their effects on soymilk quality[J].Food Science, 2015, 36(14):161-164.
[29] 吴丽樱,成玉梁,郭亚辉,等.豆腐在不同储藏温度下腐败菌菌相比较[J].食品研究与开发,2017,38(18):180-184.WU L Y, CHENG Y L, GUO Y H, et al.The comparison of spoilage microflora of tofu at different storage temperatures[J].Food Research and Development, 2017, 38(18):180-184.
[30] 李除夕,董明盛,陈晓红,等.豆腐中库特氏菌生长动力学模型和货架期预测[J].农业工程学报,2009,25(S1):82-86.LI C X, DONG M S, CHEN X H, et al.Construction of microbial growth kinetics prediction model of Kurthia in tofu and shelf life prediction[J].Transactions of the Chinese Society of Agricultural Engineering, 2009, 25(S1):82-86.
[31] LEE D Y, KWON K H, CHAI C, et al.Microbial contamination of tofu in Korea and growth characteristics of Bacillus cereus isolates in Tofu[J].LWT, 2017, 78:63-69.
[32] 李博,籍保平.葡萄糖酸内酯豆腐生产过程中微生物的变化及豆腐中主要腐败菌的鉴定[J].食品科学,2006,27(5):77-82.LI B, JI B P.Isolation and identification of major purified bacteria in glucono-δ-lactone tofu processing[J].Food Science, 2006, 27(5):77-82.
[33] ROSSI F, FELIS G E, MARTINELLI A, et al. Microbiological characteristics of fresh tofu produced in small industrial scale and identification of specific spoiling microorganisms (SSO)[J].LWT, 2016, 70:280-285.